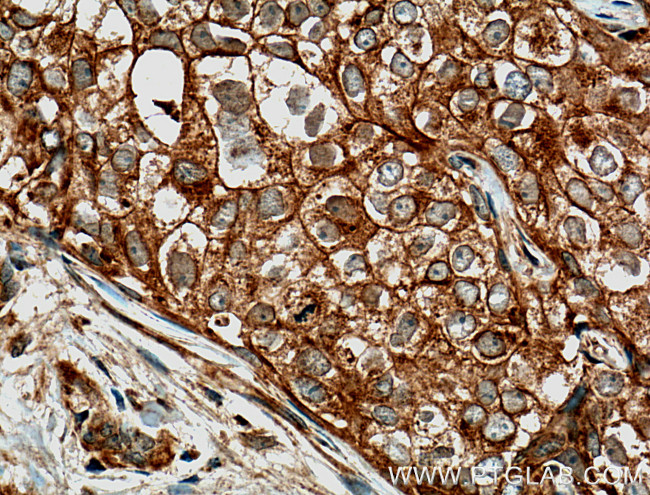
GTPBP3 Antibody in Immunohistochemistry (Paraffin) (IHC (P))

Search
Proteintech
GTPBP3 Polyclonal Antibody
{{$productOrderCtrl.translations['antibody.pdp.commerceCard.promotion.promotions']}}
{{$productOrderCtrl.translations['antibody.pdp.commerceCard.promotion.viewpromo']}}
{{$productOrderCtrl.translations['antibody.pdp.commerceCard.promotion.promocode']}}: {{promo.promoCode}} {{promo.promoTitle}} {{promo.promoDescription}}. {{$productOrderCtrl.translations['antibody.pdp.commerceCard.promotion.learnmore']}}
产品信息
10764-1-AP
种属反应
宿主/亚型
分类
类型
抗原
偶联物
形式
浓度
规格
纯化类型
保存液
内含物
保存条件
运输条件
产品详细信息
Immunogen sequence: VEFHVHGGP AVVSGVLQAL GSVPGLRPAE AGEFTRRAFA NGKLNLTEVE GLADLIHAET EAQRRQALRQ LDGELGHLCR GWAETLTKAL AHVEAYIDFG EDDNLEEGVL EQADIEVRAL QVALGAHLRD ARRGQRLRSG VHVVVTGPPN AGKSSLVNLL SRKPVSIVSP EPGTTRDVLE TPVDLAGFPV LLSDTAGLRE GVGPVEQEGV RRARERLEQA DLILAMLDAS DLASPSSCNF LATVVASVGA QSPSDSSQHL LLVLNKSDLL SPEGPGPGPD LPPHLLLSCL TGEGLDGLLE ALRKELAAVC GDPSTDPPLL TRARHQHHLQ GCLDALGHYK QSKDLALAAE ALRVARGHLT RLTGGGGTEE ILDIIFQDFC VGK (111-492 aa encoded by BC019261)
靶标信息
This locus encodes a GTP-binding protein. The encoded protein is localized to the mitochondria and may play a role in mitochondrial tRNA modification. Polymorphisms at this locus may be associated with severity of aminoglycoside-induced deafness, a disease associated with a mutation in the 12S rRNA. Alternatively spliced transcript variants encoding different isoforms have been described.
仅用于科研。不用于诊断过程。未经明确授权不得转售。
生物信息学
蛋白别名: 5-taurinomethyluridine-[tRNA] synthase subunit GTPB3, mitochondrial; GTP binding protein 3 (mitochondrial); GTP-binding protein 3; GTPBG3; GTPBP3; Mitochondrial GTP-binding protein 1; MTGP3; NTGP2; tRNA modification GTPase GTPBP3, mitochondrial; unnamed protein product
基因别名: 2410009F13Rik; AI607903; COXPD23; GTPBG3; GTPBP3; MSS1; MTGP1; THDF1
UniProt ID: (Human) Q969Y2, (Mouse) Q923K4, (Rat) Q5PQQ1
Entrez Gene ID: (Human) 84705, (Mouse) 70359, (Rat) 290633